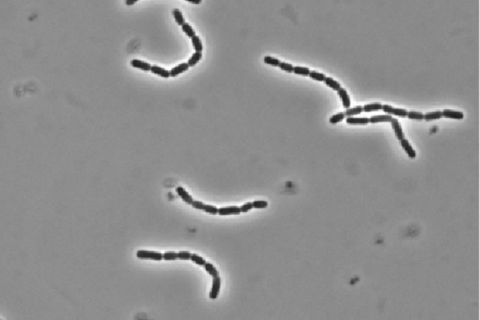
probiotic1

Using ribosome engineering (RE), researchers from Shinshu University introduced mutations affecting the protein synthesis mechanism of probiotic Lacticaseibacillus rhamnosus GG (LGG). These mutant LGGs exhibit altered surface protein expression, including increased presentation of so-called “moonlighting proteins.”
These mutants adhere more strongly to intestinal cells and induce enhanced activation of immune cells, making them “super-probiotics.” This study demonstrates the utility of RE—an inexpensive, low-risk, and rapid technique—for the enhancement of probiotic lactic acid bacteria.
Maintaining a healthy gut microbiota is an important part of good overall health. Lactic acid bacteria (LAB) are a well-known class of microorganisms that can inhibit pathogenic bacteria in the gut and support gut health. Indeed, fermented dairy products are part of healthy diets in many cultures across the globe.
Modern probiotic foods and supplements aim to maximize the health benefits of LAB without the variability of traditional fermented foods. Modifying LAB to enhance their beneficial functions represents the next stage in the development of probiotics.
The study
Professor Takeshi Shimosato from the Institute for Aqua Regeneration, Shinshu University, Japan, led a research project to enhance the probiotic characteristics of a LAB strain, Lacticaseibacillus rhamnosus GG (LGG). He was joined by Masami Tsukagoshi, Jamiyanpurev Soyolmaa, Shunsaku Nomoto, Kazuma Inoue, Masahiro Yoda, Assistant Professors Aito Murakami, Fu Namai, and Professor Takashi Sato from Shinshu University. Tomoyuki Hibi and Associate Professor Hideki Kinoshita from Tokai University, Japan, also contributed to the study.
The team used ribosome engineering (RE), a technique that induces spontaneous mutations in the cellular protein synthesis machinery. Their findings were made available online on October 27, 2025, and were published in Volume 13 of the journal Microbiology Spectrum on December 2, 2025.
“There is a growing commercial and medical demand for probiotics that do more than just ‘balance the gut’—we need strains that actively improve health outcomes. However, classical breeding methods are slow, and genetic engineering is often barred from food use,” says Prof. Shimosato. Describing the team’s use of RE, he adds, “We were inspired by the success of RE in the pharmaceutical field. We hypothesized that this technology, which ‘wakes up’ latent capabilities in bacteria by altering their ribosomes, could be repurposed to supercharge lactic acid bacteria.”
Moonlighting proteins
Prof. Shimosato’s team previously found that LGG strains with specific mutations in the ribosomal S12 protein produced higher amounts of so-called ‘moonlighting proteins’—intracellular proteins that have additional functions when they appear on the bacterial cell surface.
“The K56N mutant displayed increased expression of the moonlighting protein Glyceraldehyde-3-phosphate dehydrogenase (GAPDH) on its surface and showed enhanced adhesion to human colonic mucin via GAPDH-mediated binding,” said Prof. Shimosato, adding, “The present study extends this investigation by exploring how the K56N mutation affects extracellular vesicle (EV) composition and host immune modulation.”
In the current research, the team found that K56N mutants had 23 distinct surface proteins, whereas wild-type (WT) LGG had only five. Importantly, K56N mutants had significantly higher amounts of surface GAPDH than WT. When cultured with HT-29 immortalized human intestinal cells, twice as many K56N mutant bacteria adhered to HT-29 cells as WT. When used therapeutically, K56N cells would be better at remaining in the gut and displacing pathogenic bacteria from the intestinal surface.
Immunostimulatory effects
The team then compared the immunostimulatory effects of K56N and WT surface proteins. When added to RAW 264.7 mouse macrophage cultures, K56N EVs induced much higher secretion of tumor necrosis factor α (TNF-α) than WT EVs. TNF-α is a key chemical messenger that stimulates immune responses. Four surface proteins from K56N mutants increased TNF-α secretion, whereas only one WT protein—GAPDH—did the same. Potentially, K56N mutants could increase immune responses in the gut and clear pathogens more quickly.
These findings show that K56N mutants are possible “super-probiotics,” since they could colonize the gut more effectively and have greater immunostimulatory effects than wild-type LGG. These factors may help individuals whose gut metabolism might flush out WT LGG too quickly. K56N mutants could be used to create more effective probiotic foods, immune-enhancing supplements, and immunity-boosting feed additives for livestock and aquaculture. Even K56N EVs had immunostimulatory effects, which means they can be used as non-living vaccine adjuvants.
Promising candidates
While further studies are needed to identify the specific proteins that increase K56N adhesion and immunostimulatory effects, this study validates the efficacy of RE as a technique to enhance the probiotic characteristics of LAB.
“As ribosome-engineered LGG mutants can be obtained easily and safely and exhibit enhanced robustness and functionality, they are promising probiotic candidates,” concludes Prof. Shimosato.
No comments yet